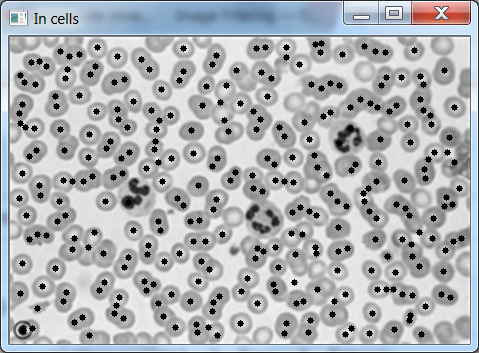
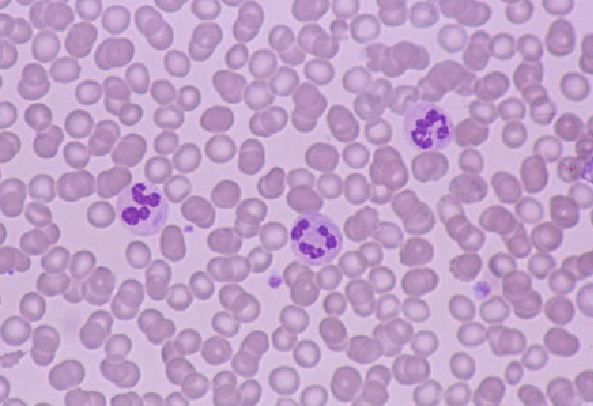

我正试着在显微镜图像上计算红细胞的数量。这些是较小的细胞。(我第一次尝试使用CNN和滑动窗口,但是太慢了,所以我想找一个更简单的分段)
我的方法是:
我的问题是,一些细胞在中间明亮的区域有一个“洞”,与背景值相似。如果我对图像进行阈值化,一些细胞掩膜就会变成一个半圆而不是一个圆圈,其距离转换值远低于预期值。
我在面具图像上标记了有“洞”的细胞。
我能把洞或圆圈关上吗?有门限方法或技巧吗?
下面是代码中负责单元格提取的部分:
cv::adaptiveThreshold(_imgIn ,th, 255, ADAPTIVE_THRESH_GAUSSIAN_C, (bgblack ? CV_THRESH_BINARY: CV_THRESH_BINARY_INV), 35, 5 );//| CV_THRESH_OTSU);
Mat kernel1 = Mat::ones(3, 3, CV_8UC1);
for (int i=0; i< 5;i++)
{
dilate(th, th, kernel1);
erode(th, th, kernel1);
}
vector<vector<Point> > contours;
findContours(th, contours, CV_RETR_EXTERNAL, CV_CHAIN_APPROX_NONE);
mask = 0;
for( unsigned int i = 0; i < contours.size(); i++ )
{
drawContours(mask, contours, i, Scalar(255), CV_FILLED);
}
cv::distanceTransform(mask, dist, CV_DIST_L2, 3);
}
double min, max;
cv::Point pmax;
Mat tmp1 = dist.clone();
while (true)
{
cv::minMaxLoc(tmp1, 0, &max, 0, &pmax);
if ( max < 5 )
break;
cv::circle(_imgIn, pmax, 3 , cv::Scalar(0), CV_FILLED );
cv::circle(tmp1, pmax, max , cv::Scalar(0), CV_FILLED );
}

发布于 2020-05-06 08:06:39
闭孔
正在关闭是数学形态学领域的一个重要算子。就像它的对偶算子开一样,它可以从侵蚀和膨胀的基本操作中导出。与这些操作符一样,它通常被应用于二进制图像,尽管有灰色版本。闭合在某些方面类似于膨胀,因为它倾向于扩大图像中前景(明亮)区域的边界(并缩小这些区域的背景色孔),但对原始边界形状的破坏较小。与其他形态学算子一样,精确的运算是由结构元素决定的。操作符的作用是保留与此结构元素形状相似的背景区域,或者可以完全包含结构元素的背景区域,同时消除背景像素的所有其他区域。
在Open中如下所示:
import cv2 as cv
import numpy as np
img = cv.imread('j.png',0)
kernel = np.ones((5,5),np.uint8)
erosion = cv.erode(img,kernel,iterations = 1)
closing = cv.morphologyEx(img, cv.MORPH_CLOSE, kernel)

完整文档这里。
https://stackoverflow.com/questions/51113773
复制相似问题